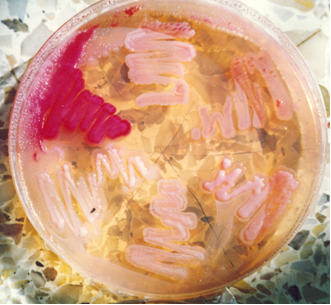
Serratia marcescens (a las 10), E.coli (a las 12, a las 2 y a las 6). Grupo KES (a las 4 y a las 8).

Mac CONKEY AGAR, medio clásico para detección de E.coli y demás coliformes en muestras clínicas y medicamentos (y en cosmética, error ISO)
PHARMACOPEA MEDIO H
Aislamiento y detección de Coliformes (USP, APHA, FDA, ISO 21150 cosméticos)
COMPOSICIÓN
Serratia marcescens (a las 10), E.coli (a las 12, a las 2 y a las 6). Grupo KES (a las 4 y a las 8).
Peptona pancreática de gelatina 17,0 g
Triptona 1,5 g
Peptona de carne 1,5 g
Lactosa 10,0 g
Sales biliares 1,5 g
Cloruro sódico 5,0 g
Rojo neutro 30,0 mg
Cristal violeta 1,0 mg
Agar agar 13,5 g
(Fórmula por litro)
pH final: 7,1 ± 0,2
PREPARACIÓN
Disolver 50 g de medio en 1 litro de agua destilada.
Calentar lentamente hasta ebullición, agitando para su completa disolución.
Repartir en tubos ó frascos.
Autoclavar a 121 ºC durante 15 minutos.
PARA USO EXCLUSIVO EN LABORATORIO.
AGITE EL BOTE ANTES DE USAR.
MANTENGA EL BOTE BIEN CERRADO EN LUGAR SECO, FRESCO Y OSCURO.
PRECAUCIÓN: CONTIENE SALES BILIARES.
DESHIDRATADO CODIGO: DMT073
CONTROL DE CALIDAD DEL MEDIO
Realizado en nuestro laboratorio; es prudente repetirlo en su laboratorio siempre que varíen las condiciones (más de 3 meses sin usar, tras desinfectar laboratorio, tras conservar a alta Tª, cuando adquiere aspectos extraños aunque no haya llegado la fecha de caducidad teórica de la etiqueta,…)
DESHIDRATADO: Polvo, púrpura
PREPARADO: Estéril, Púrpura
CONTROL DE CRECIMIENTO 24-48 h a 37°C aproximadamente:
- Enterobacter aerogenes MKTA 9489, Excelente , Colonias rojas.
- Klebsiella oxytoca MKTA 13182, Correcto, colonia roja con precipitado.
- Salmonella abony MKTN 6017, Excelente, Colonias incoloras. Con respecto a TSA estandarizado, recuento 100%.
- Shigella flexneri MKTA 12022, Bueno, colonias incoloras
- Escherichia coli MKTA 25922, Excelente, Colonias rojas con precipitado. Con respecto a TSA estandarizado, recuento 95%.
PRESENTACIÓN: TUBOS 20 ml, FRASCOS 100 y 250 ml, MEDIO DESHIDRATADO.
NOTA: Medio selectivo y diferencial para el aislamiento de las enterobacterias y para la diferenciación entre los coliformes y las enterobacterias patógenas que no fermentan la lactosa con producción de gas (APHA, FDA, USP XXI). Su selectividad se debe a la acción del Cristal Violeta y de las sales biliares.
SIEMBRA
En estría sobre la placa preparada o el tubo de agar inclinado. Con los tubos 20 ml y frascos 100 ml se preparan placas por fusión del medio. Las Placas de Contacto se aplican sobre la superficie problema, un instante y sin mover, o bien se introducen en un aparato para control del aire. Incubar a 37 ºC aproximadamente, durante 16 24 horas.
INTERPRETACIÓN
Los coliformes crecen con colonias rojas rodeadas por un halo de precipitación de las sales biliares, por acidificación. Las otras enterobacterias crecen con colonias incoloras. Proteus no invade la placa. E. coli forma colonias rojo violáceas con halo. Enterobacter aerogenes crece menor que E.coli y sin halo. Salmonella crece incolora.
El usuario final es el único responsable de eliminar los microorganismos de acuerdo con la legislación medioambiental vigente. Autoclavar antes de desechar a la basura.
https://www.microkit.es/fichas/Mac-CONKEY-AGAR.pdf
Si desea más información sobre nuestros Mac CONKEY AGAR, rellene nuestro formulario de contacto http://www.medioscultivo.com/contacto . O si lo prefiere póngase en contacto con nosotros a través de nuestro correo electrónico microkit@microkit.es o por teléfono en el nº 91-897 46 16

